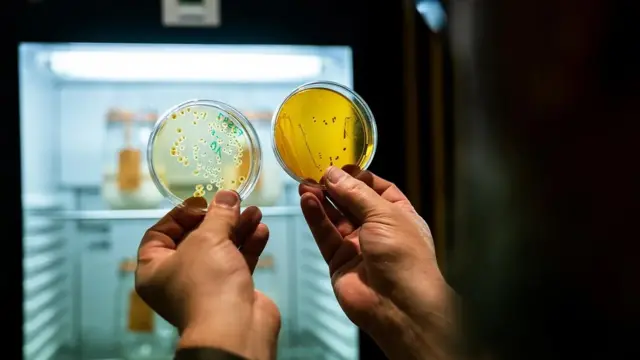
De Smed radi sa Gobetijem na izolovanju sojeva kvasca i bakterija te njihovom zamrzavanju

Hrana i istorija: Koje je najstarije kiselo testo na svetu

Autor fotografije, alvarez/Getty Images
- Autor, Pol Fajnstin
- Funkcija, BBC Budućnost
Tokom pandemije, mnogi ljudi su se prvi put upustili u istraživanje umetnosti pravljenja hleba.
Neki su koristili suvi aktivni kvasac ili sodu bikarbonu da bi pronašli to savršeno dizanje testa, dok su se drugi okušali u divljem svetu kvasaca od kiselog testa.
Ali domaći pekari nisu samo naučili da prave hleb u najprirodnijem obliku - oni su dotakli antički život.
Kvasac za kiselo testo, koje se često naziva matičnim testom, ima skoro 6.000 godina dugu istoriju koja se proteže širom sveta i odgovoran je za ishranu planete milionima puta.
Ovo testo očarava pekare, naučnike i istraživače koji žele da shvate kako je nastao ovaj eliksir života i šta ga čini tako posebnim - posebno kada vlasnik kvasca tvrdi da ima dugu istoriju.
Zbog ove fascinacije, stari kvasci imaju gotovo mističan kvalitet, a njihovo pronalaženje i pečenje zaokupilo je domaće kuvare i profesionalce širom sveta.
Potraga za najstarijim kvascem za kiselo testo obuhvata kontinente i zemlje, naučne laboratorije i biblioteke i uključuje sve, od starih Egipćana do Isusa Hrista.
Ovo je potraga za pronalaženjem najstarijih majki na planeti - živog, dišućeg kvasca punog mehurića, za kiselo testo koje je pomoglo u izgradnji piramida, nahranilo Rimsko carstvo i podstaklo zlatnu groznicu.
Za neupućene, hleb od kiselog testa se pravi sa kvascem za kiselo testo.
Kvasac je sredstvo za dizanje koje pomaže da hleb naraste kada je pečen.
Najjednostavnije rečeno, kvasac se formira kada kombinujete vodu i brašno i dozvolite prirodnim gljivicama i bakterijama koje lebde u vazduhu da se kombinuju i počnu da fermentiraju.
Vremenom, kvasac će potrošiti ugljene hidrate u brašnu i pretvoriti ih u ugljen-dioksid, što je ono što kiselom testu daje mehuriće.

Autor fotografije, Grahamphoto23/Getty Images
Kao i kvasac, bakterije takođe konzumiraju ugljene hidrate, ali umesto mehurića, njihov nusproizvod je mlečna kiselina, koja daje kiseli ukus kiselom testu.
Rezultat je živi organizam koji je jednak kućnom ljubimcu koji zahteva hranjenje i negu vodom, brašnom i prijatnim temperaturama za rast.
Poput penušavog taloga fermentirajućeg kvasca za kiselo testo, istorija pravljenja hleba od kiselog testa je nejasna.
Prema istoričarima i arheolozima, rasprostranjeno pečenje hleba je zaista počelo pre oko 5.000-6.000 godina u starom Egiptu.
Na svim grobnicama i hramovima možete pronaći hijeroglife farmera koji sakupljaju pšenicu i peku vekne hleba.
Ali da li su Egipćani koristili kvasac?
Prema doktorki Sereni Lav, gastro-egiptološkinji, to nije dokazano.
„Tokom doba piramida, dakle 2.500 godina pre nove ere, kada su se gradile piramide oko Gize i ceo taj kompleks, ono što imamo su tekstualni izvori koji kažu da su (radnici) dnevno dobijali hleb, pivo i luk.
„A kada govorite o 10.000 ljudi koji su tamo živeli, pravite mnogo hleba."
Iako je nepoznato da li su Egipćani namerno koristili pravi kvasac za pravljenje hleba, pekari su u to vreme možda slučajno upotrebili neku od mešavina brašna i vode od prethodnog dana i stavili da se peče sledećeg dana.
Dakle, prema Lavovoj, „možete to nazvati kiselim testom, oni prave hleb, a onda će uzeti malo (testa) i koristiti ga za sledeće pravljenje…".
„Oni još uče kako da to rade u masovnim razmerama".

Autor fotografije, Album/Alamy
Za stvarni dokaz o pečenju kiselog testa, morate premotati vreme nekoliko hiljada godina unapred, do Starog Rima, i pročitati tekstove rimskog istoričara Plinija Starijeg oko 77. godine naše ere.
Profesor Erik Palant, autor knjige Kultura kiselog testa: Istorija pravljenja hleba od drevnih do modernih pekara, kaže da je ovo prvi zabeleženi primer dizanja testa sa kvascem za hleb.
„Ovo je zapisao Plinije Stariji. Rimljani u suštini govore da možete praviti hleb i možete ga naterati da naraste.
„I ako sačuvate nešto (testa) od juče, (možete) da ga stavite u današnji hleb. To je prvi zapisani recept u koji sam prilično siguran", rekao je Palant.
Majkl Ganzl, mikrobiolog za hranu sa Univerziteta Alberta u Kanadi, koji radi na nauci o kiselom testu više od 20 godina, podržava Palantovo istraživanje i dodaje novi sastojak mešavini.
„Koliko znam, najstariji dokument (koji govori o) 'mešenju' star je otprilike 2.000 godina, a postoje dva izvora.
„Jedan je Plinije Stariji, koji je pisao o kiselom testu i eksplicitno pominje mešenje, što znači korišćenje dela od testa prethodnog dana i pravljenja sledećeg kiselog testa", rekao je Ganzl.
„Drugi pouzdan izvor je Novi zavet."
Ako pretražujete po jevanđeljima, naći ćete brojne reference na kvasac, koji bi zahtevao mešenje da bi se napravio hleb.
Među primerima je jevanđelje po Luki 13:20/21: Ponovo je upitao: „S čim da uporedim Carstvo Božije? To je kao kvasac koji je žena uzela i pomešala u tri mere brašna dok se sve ne ukiseli."
Ili, u Mateju 13:33: „Carstvo nebesko je kao kvasac koji je žena uzela i umešala sa oko šezdeset grama brašna dok se ne razradi celo testo."
Ganzl je nastavio: „Ako pogledate priču o kiselom testu (u Novom zavetu), način na koji se priča koristi implicira da je kiselo testo korišćeno kao kultura kvasca. I bez obzira na to šta mislite o Bibliji, činjenica da neko u 1. veku pominje (kvasac)... znači da se (mešenje sa kvascem za kiselo testo) već uobičajeno radilo u to vreme."
Autor fotografije, Puratos Center for Bread Flavour
Iako kvasac za kiselo testo ima istoriju isprepletenu sa starim Egiptom i Rimom, da li i danas postoje neki potomci ovih originalnih kvasaca?
Nažalost, ne postoji 23 and Me ili Ancestry.com za kiselo testo.
Profesor Marko Gobeti, mikrobiolog sa Slobodnog univerziteta u Bolcanu, u Italiji, jedan je od vodećih svetskih naučnika o kiselom testu i objašnjava zašto nije moguće naučno dokazati starost kvasca za kiselo testo.
„Danas koristimo najsofisticiranije alate da izvršimo ovu analizu. Možemo da damo imena bakterijama mlečne kiseline i kvascu, ali ne možemo da razumemo koliko je kiselo testo staro", rekao je Gobeti.
„Zašto? Zato što život mikroba ne traje duže od jednog dana."
Ali ta naučna činjenica nije sprečila pekare i entuzijaste za kiselo testo širom sveta da daju neverovatne tvrdnje o kvascima starim više od 100 godina ili onima koji datiraju iz srednjeg veka i ranije.
I postoje takve priče.
Poput Šejmusa Bleklija, pronalazača Iksboksa, koji je ostrugao kvasac sa egipatske grnčarije stare 5000 godina i od nje napravio kiselo testo.
Ili izraelski tim na čelu sa Ronenom Hazanom, mikrobiologom sa Hebrejskog univerziteta u Jerusalimu, koji je napravio pivo od kvasca pronađenog u drevnim glinenim posudama.
Zatim, tu su i prodavci na Ibeju i Etsiju koji tvrde da poseduju kvasce koji datiraju iz vremena Crne smrti ili trgovaca na Putu svile pre više od 900 godina.
Dakle, ako ne možete naučno utvrditi starost kvasca za kiselo testo, kuda to vodi?
Neizbežno mesto gde se katalogizuju priče, koje ovu potragu vodi u Belgiju i Puratos centar za ukus hleba - jedinu svetsku biblioteku kiselog testa - u kojoj žive neke zaista stare i zaista retke majke.
Biblioteku za kiselo testo Puratos, koja se nalazi oko 145 kilometara jugoistočno od Brisela, vodi Karl De Smed, pekar koji ima zadatak da čuva najređe i najstarije kvasce za kisela testa na svetu.
„Ono što radimo su tri stvari. Čuvamo biodiverzitet kiselog testa, štitimo nasleđe i nudimo rezervu onima koji nam daju uzorak svog kvasca za kiselo testo", rekao je on.
De Smed radi sa profesorom Gobetijem, mikrobiologom za kiselo testo iz Italije, na izolaciji sojeva kvasca i bakterija i njihovom zamrzavanju (što mikroorganizme dovodi u stanje hibernacije), kako bi se mogli sačuvati zauvek.
Njegovi nalazi odražavaju rezultate drugih mikrobiologa širom sveta u tome što se slični sojevi kvasca i bakterija pojavljuju svuda i ne postoji način da se zna koliko je bilo koji kvasac zapravo star.

Autor fotografije, Puratos Center for Bread Flavour
„Ne možete odrediti starost kiselog testa. Kada dobijem kiselo testo od nekoga, moram da mu verujem", kaže on.
Ali samo zato što naučnici tehnički ne mogu da otkriju starost kvasca, De Smed i dalje veruje da nekoliko kvasaca u njegovim trezorima imaju neke vekovne zasluge.
„Imam ih par ovde. Jedan dolazi iz Zlatne groznice u Klondajku.
„Dakle, datira iz 1896. godine. Jedan iz Švajcarske seže šest generacija unazad, a pekara je osnovana 1868.
„Imam još jedan iz Japana, koji je iz 1875. Ali ne dolaze sa izvodom iz matične knjige rođenih. Dakle, nemoguće je (da budemo sigurni)", rekao je De Smed.

Pogledajte video o slavskom kolaču

Kao istinski vernik kiselog testa i uprkos trenutnim naučnim preprekama, De Smed nastavlja da traga za retkim i starim kvascima.
„Potraga za kiselim testom podrazumeva da izađemo i pronađemo kiselo testo koje još postoji i koje bismo mogli da proučavamo ovde u biblioteci.
„To je veoma teško, jer koje je najređe? To još ne znamo. Nadam se da ću ga pronaći."
Za De Smeda - i mnoge druge - priče o kvascu su možda važnije od samog kvasca.

Autor fotografije, Puratos Center for Bread Flavour
Uzmimo primer Danijelea Uditija, raznosača pica iz Kazerte, u Italiji, koji je prokrijumčario skoro 70 godina star kvasac porodične pekare u Los Anđeles i koristi ga da formira savršenu koru na svojim neo-napuljskim pitama u nagrađivanoj piceriji Picana.
Tu je Ajoni Kristensen, 89-godišnja pekarka iz Vajthorsa u Kanadi, koja tvrdi da hrskavi, ukusni vafli od kiselog testa koje pravi kod kuće potiču od kvasca koji datira iz Zlatne groznice u Klondajku.
„Pa, mogu to sa sigurnošću pratiti do 1898. To je bilo kada su pradeda i njegova četiri sina napustili Sent Džons, Nju Branzvik, u februaru 1898. zbog Zlatne groznice na Klondajku", rekla je Kristensenova… ,,I od tada je taj kvasac u našoj porodici."
U Japanu, pekara Kimuraja koristi jedinstveni kvasac napravljen od kuvanog pirinča, pirinčanog slada i vode za hleb An Pan koji prave od 1870-ih i vole ga i japanski carevi i obični ljudi.
Čuvena italijanska kuvarica i autorka kuvarica Sara Papa tvrdi da ima kvasac iz Milana koji datira iz 1848. godine i da ga koristi za pucketave, mekane vekne od kiselog testa.

Autor fotografije, Arianna Sikorski
A tu je i Arijana Sikorski, iz Aljaske, koja je nasledila poseban kvasac Zlatne groznice u Klondajku koji datira iz 1890-ih i putuje sa njom po celom svetu, deleći ga sa kolegama entuzijastima za hleb.
„U smislu dokaza, nemamo fotografiju iz 1896. godine kada je prvi put nastao u nekom šatoru.
„Mogu da dokažem samo ono što sam videla kada sam bila mala, u smislu da smo to uvek koristili.
„Živela sam u kolibi, to je bio naš glavni izvor hrane neko vreme. I moji roditelji su ga uvek održavali aktivnim i živim", rekla je Sikorski.
Lista se nastavlja porodičnim pričama i pekarskom poreklu kojima je nemoguće ući u trag, a svi dolaze sa folklorom.
Ali kada je u pitanju verifikacija, samo nekolicina ima dovoljno podataka da potvrde svoje tvrdnje.
„U mom svetu postoje dva verodostojna izveštaja o kiselom testu koje je starije od 100 godina", rekao je Ganzl.
„Jedan bi bio pekara Budan u San Francisku. Reći će vam da održavaju kiselo testo od zlatne groznice 1849.
„I mislim da je to savršeno razumno i verodostojno. Jer znam da, ako pekar preda pekaru nekom drugom u porodici ili van porodice, kvasac ostaje".

Autor fotografije, Boudin Bakery
„Drugi dokumentovani slučaj koji dolazi sa laboratorijskim knjigama i svim ostalim, jeste nemački proizvođač kulture kvasca po imenu Beker", objasnio je Ganzl.
„Oni imaju, barem u Nemačkoj i okolnim zemljama, prilično snažnu reputaciju da prodaju dobru kulturu kvasca.
„I propagiraju svoje kiselo testo, čini mi se, od 1906. I imaju dokumentaciju da se ovo kiselo testo neprekidno razmnožava najmanje 100 godina. Skoro 120."
Ali jedna od najzanimljivijih priča o kiselom testu dolazi sa veoma neverovatnog mesta. U potrazi za poreklom kiselog testa, autor Erik Palant otkrio je crkvu u Siriji koja iznosi fascinantnu tvrdnju.
„Nestorijanci, koji su u Asiriji, insistiraju, na osnovu sopstvenih svetih spisa, da njihov kvasac zapravo potiče od Hristovih suza na krstu i njegove krvi nakon što su ga Rimljani uboli.
„(Apostol) Jovan je zadržao (tu krv i i suze) i (napravio) kiselo testo. (Odatle) su apostoli delili (taj kvasac), a ova crkva (u Siriji) još koristi evharistiju", rekao je Palant.
„Dakle, kada Isus kaže, moje telo je hleb, a moja krv je vino - što su oboje proizvodi fermentacije - nestorijanci insistiraju da to zaista jeste baš tako!".

Autor fotografije, San Francisco Chronicle/Hearst Newspapers/Getty Im
Da li je „sveti gral" istorijskih kvasaca koji je tada bio sakriven na vidnom mestu sve vreme, unutar crkve u Siriji, hiljadama puta mešen i davan kao sveto pričešće opet i iznova?
Malo je verovatno.
I bez obzira da li pruža „večni život" pobožnim vernicima crkve koji ga konzumiraju, kvasac je možda postigao nivo besmrtnosti - u obliku vode, brašna, kvasca i bakterija - koji se može suprotstaviti svakoj priči o Fontani mladosti ili čaši Hristovoj.
Dakle, ko ima najstariji kvasac na svetu?
Kratak, naučni odgovor je niko.
Međutim, ako ste ljubitelj dokumentacije, Beker u Nemačkoj, Budan u San Francisku i verovatno pekara Kimuraja u Japanu imaju pravo na nagradu.
Anegdotski, najstariji, možda najteže za poverovati kvasac moguće ima tragove DNK samog Isusa Hrista.
Ali ako mikrobiolozi ikada pronađu novi način da potvrde mitološke tvrdnje o poreklu kvasca, biblioteka Puratos u Belgiji će možda morati da izgradi veće krilo za najstarije, najređe majke na Zemlji.

Pogledajte video: Gde je završio sav taj kvasac tokom pandemije

Pratite nas na Fejsbuku,Tviteru i Vajberu. Ako imate predlog teme za nas, javite se na [email protected]












